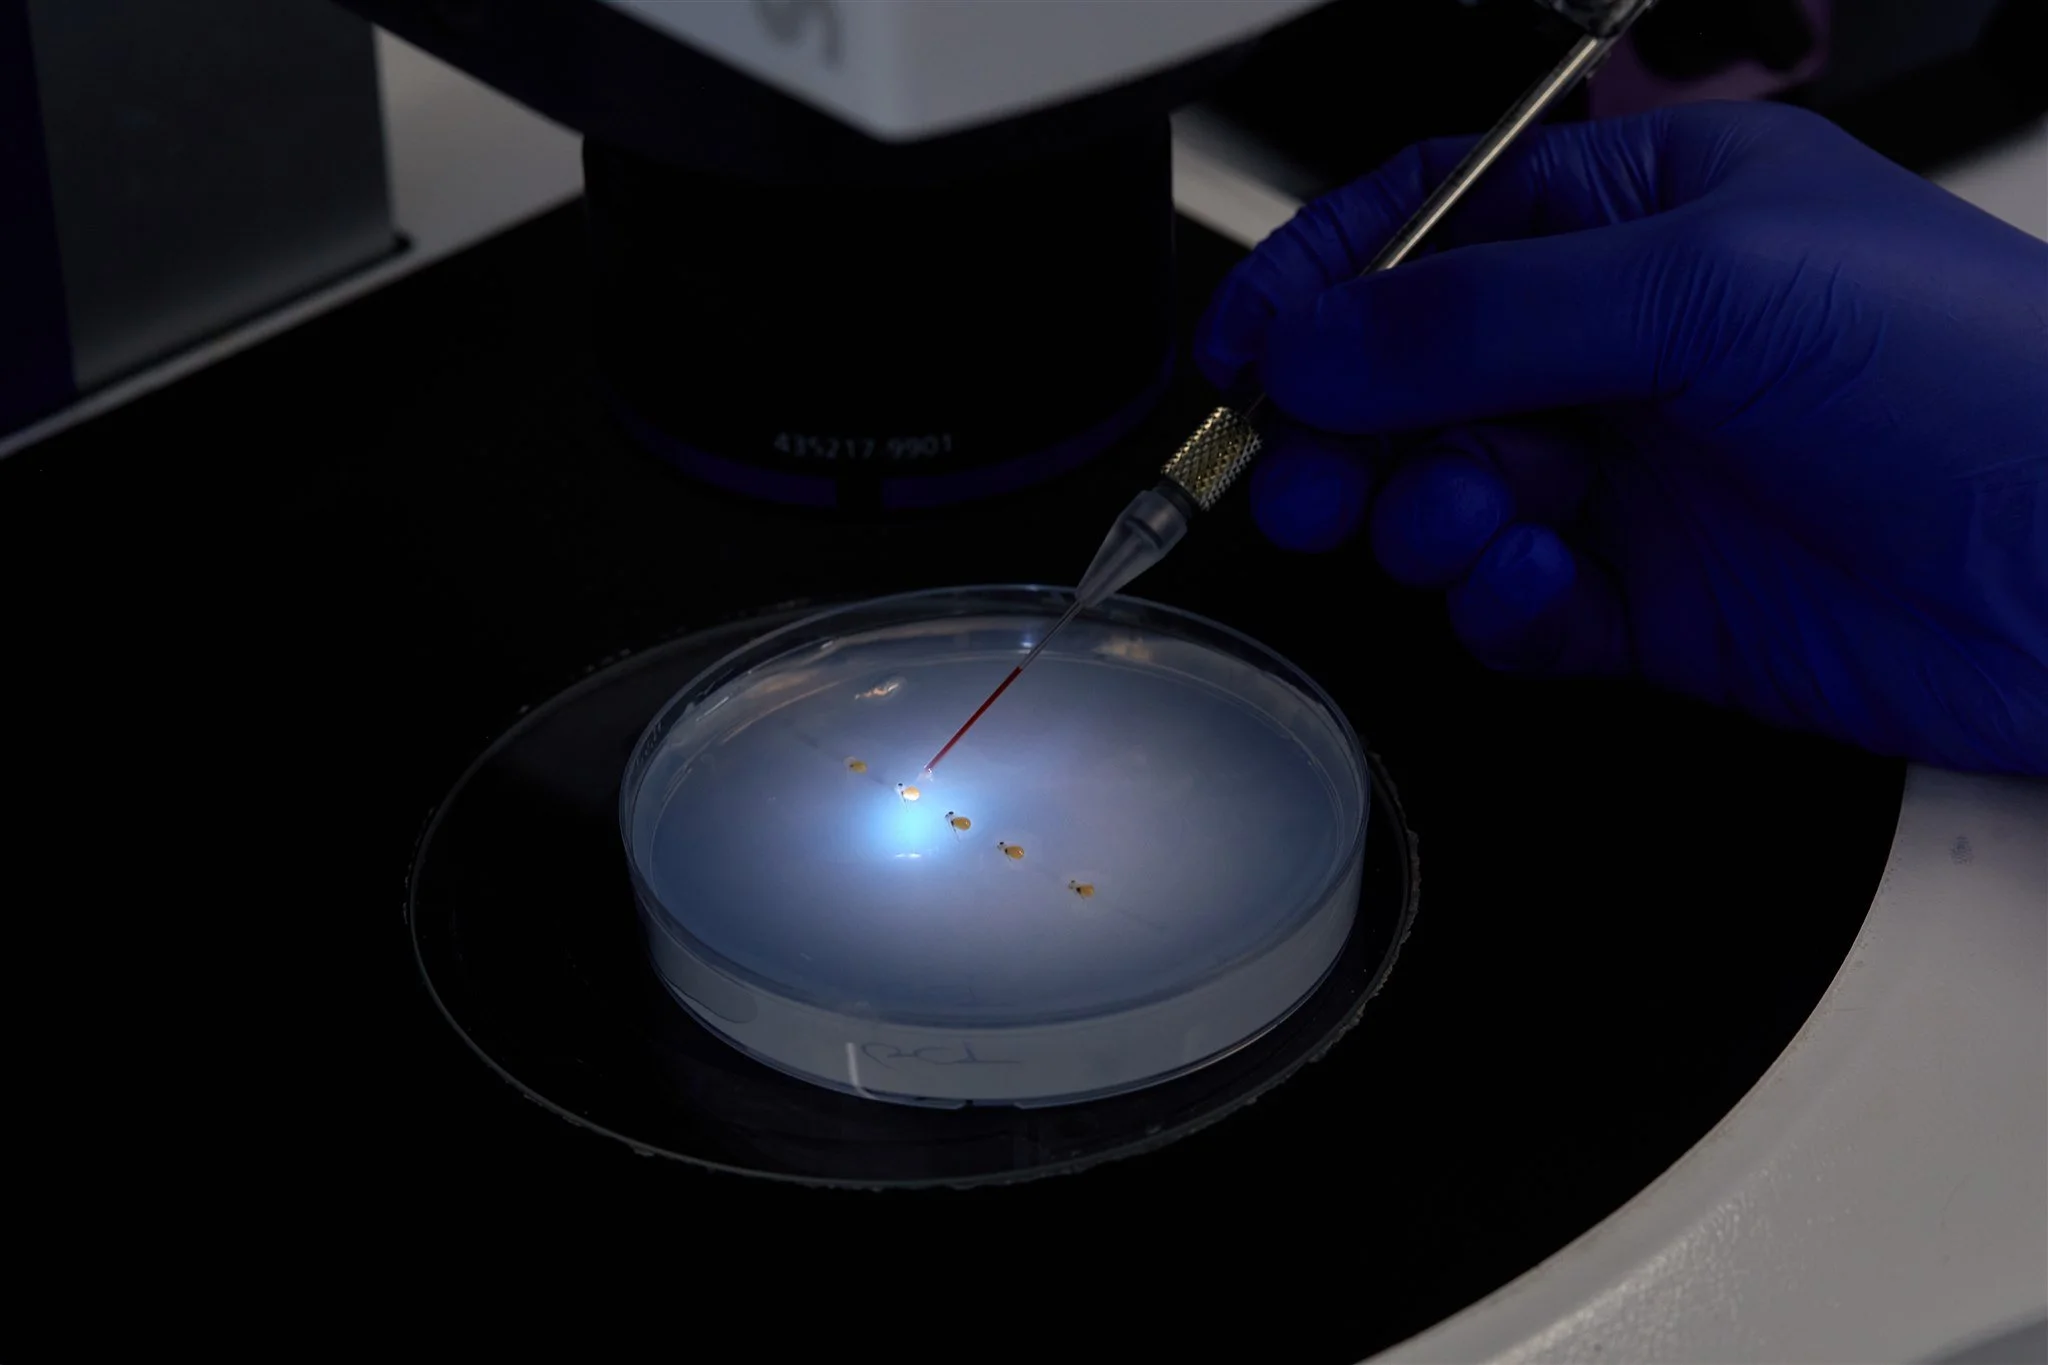

INNOVATION PARTNER
The Center for Aquaculture Technologies (CAT)
Center for Aquaculture Technologies (CAT) is the global leader in aquaculture genetics, serving as a premier innovation partner for producers seeking to unlock the full potential of their biomass.

CAT provides a comprehensive suite of integrated genetic services, including high throughput genotyping, advanced genomic analysis, and tailored selective breeding program design. At the core of their offering is Next-Gen Breeding, an industry leading strategy that combines these disciplines to fast track genetic progress.
As a pioneer in genome editing, CAT offers a transformative, non-transgenic path toward a more resilient aquaculture sector. By utilizing non-transgenic methods that mimic natural genetic variation, they provide a sophisticated tool for enhancing industry sustainability. This innovation drives significant environmental impact through sterility technology, providing a reliable foundation for long-term resource management. Beyond sterility, genome editing enhances natural disease resistance and helps species adapt to changing environments, offering expansive opportunities to improve the industry.
With state-of-the-art facilities and expertise in over 35 species, CAT ensures clients remain at the forefront of the global market. Through a partnership driven model, CAT ensures these breakthroughs translate directly into commercial success, helping clients achieve more stable and productive operations.